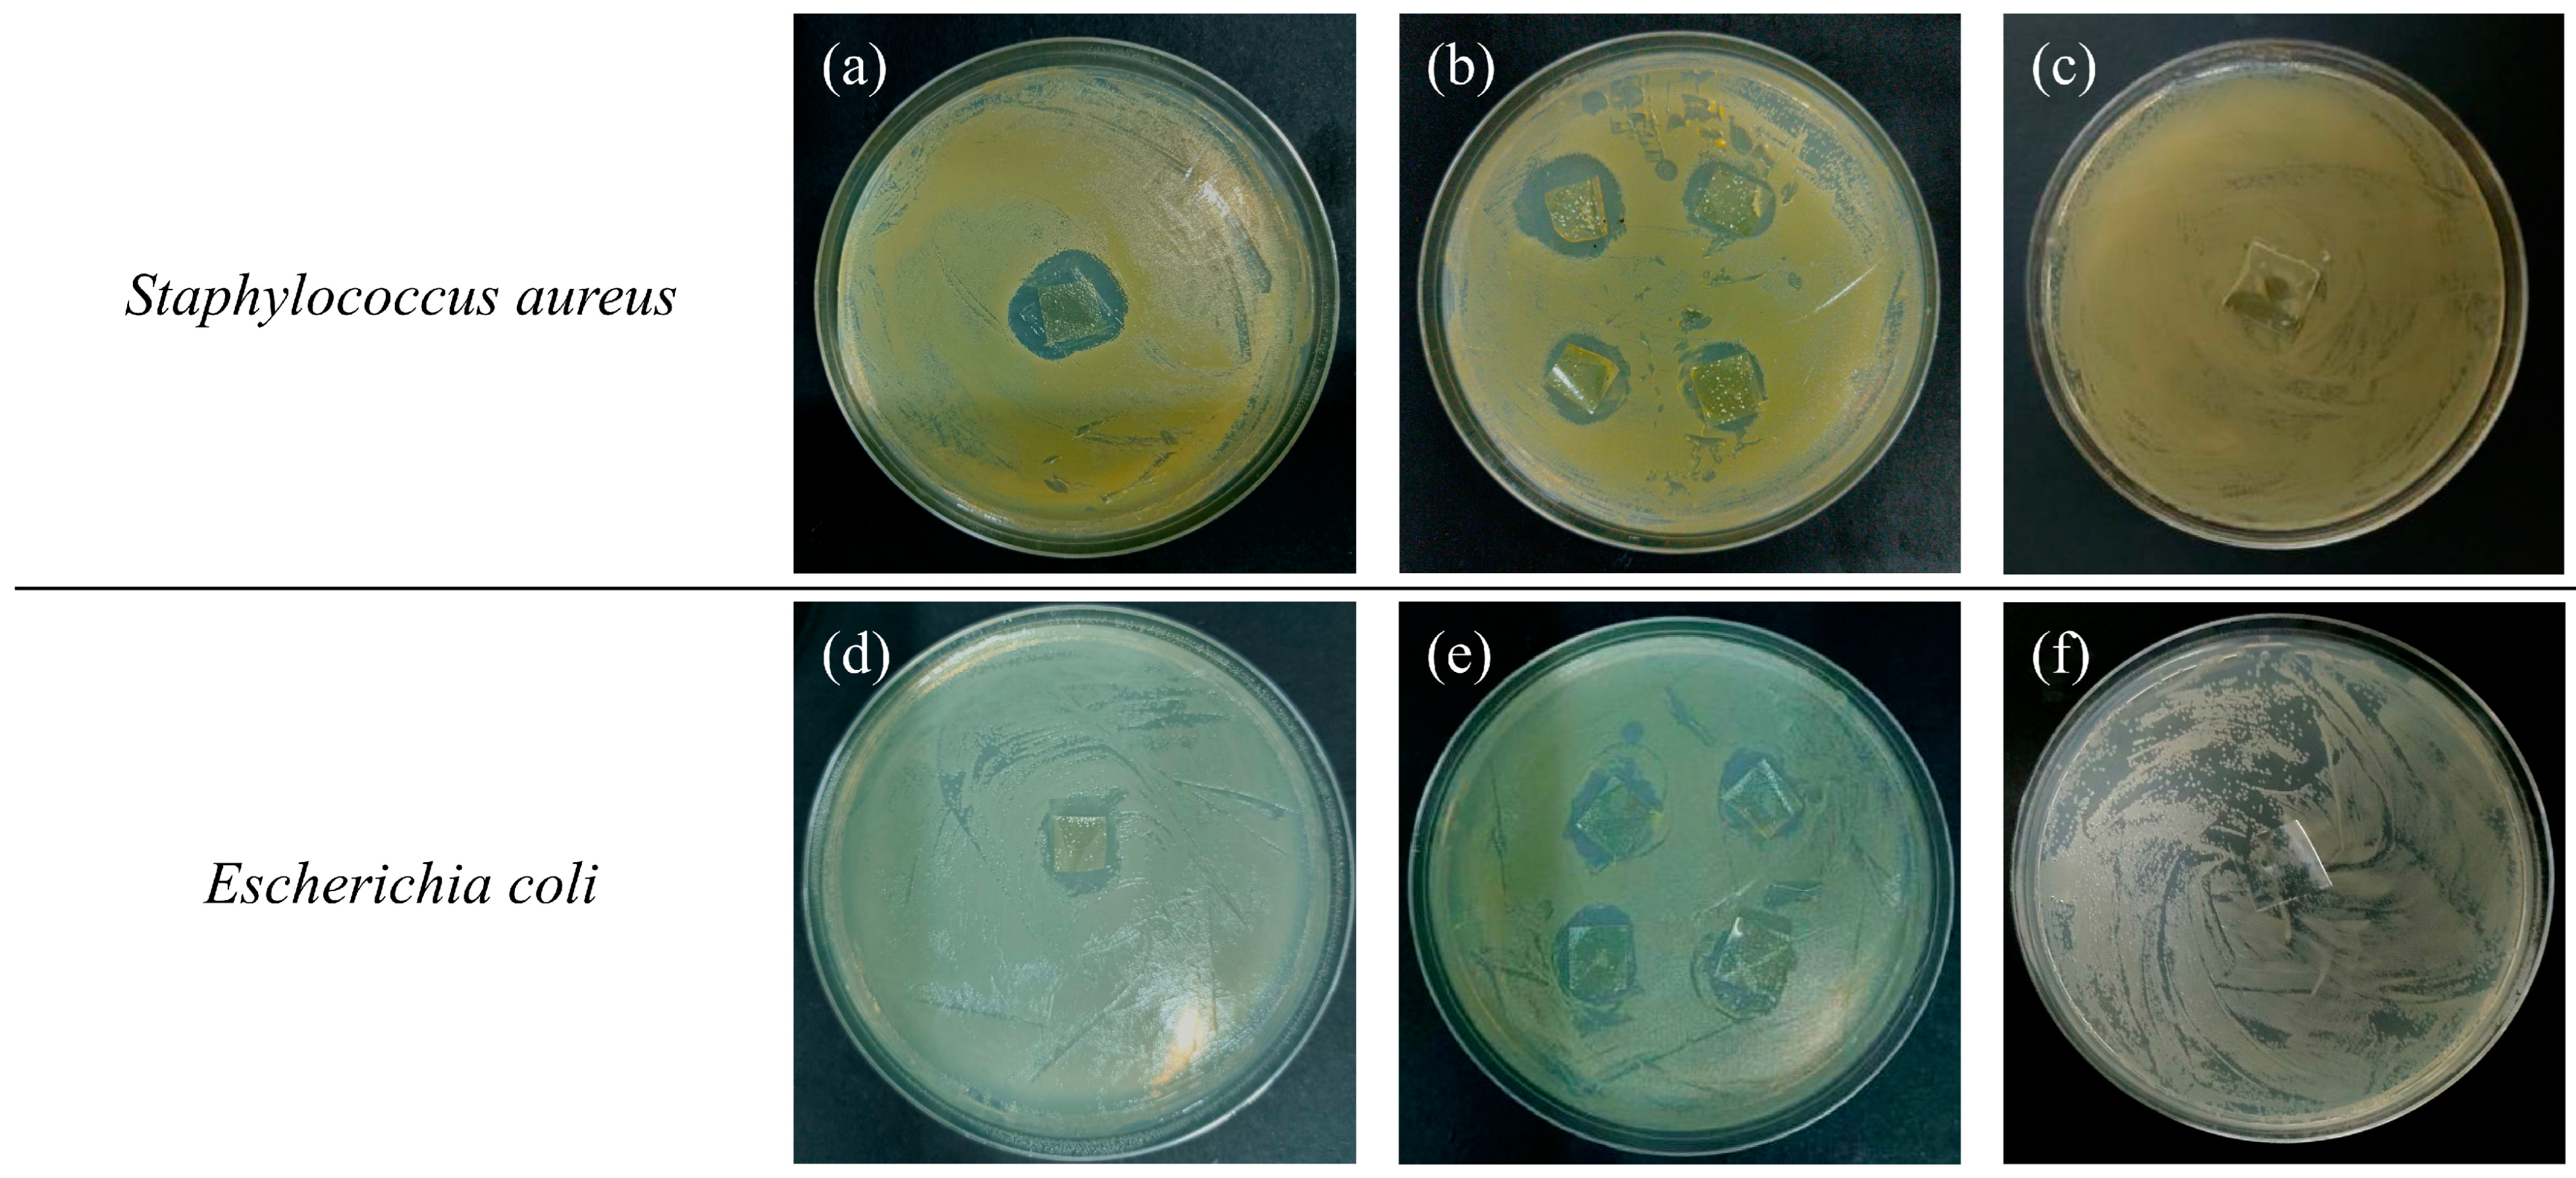
Ijms 25 08125 g005

Excellent Antibacterial Properties of Silver/Silica–Chitosan/Polyvinyl Alcohol Transparent Film
Abstract
1. Introduction
2. Results and Discussion
2.1. Optical Properties
2.2. Mechanical Properties
2.3. Micromorphology
2.4. FTIR
2.5. XRD
2.6. Antimicrobial Activity
2.7. Thermogravimetric Properties
2.8. Water Contact Angle
3. Materials and Methods
3.1. Materials
3.2. Preparation of Ag/SiO2 Nanoparticles
3.3. Preparation of CS-PVA Film
3.4. Preparation of Ag/SiO2-CS-PVA Film
3.5. Characterization
4. Conclusions
Supplementary Materials
Author Contributions
Funding
Institutional Review Board Statement
Informed Consent Statement
Data Availability Statement
Conflicts of Interest
References
- Rai, M.; Ingle, A.P.; Gupta, I.; Pandit, R.; Paralikar, P.; Gade, A.; Chaud, M.V.; dos Santos, C.A. Smart nanopackaging for the enhancement of food shelf life. Environ. Chem. Lett. 2019, 17, 277–290. [Google Scholar] [CrossRef]
- Ge-Zhang, S.; Chen, X.; Zhu, H.; Song, Y.; Ding, Y.; Cui, J. Computer Simulation of Polyethylene Terephthalate Carbonated Beverage Bottle Bottom Structure Based on Manual-Automatic Double-Adjustment Optimization. Polymers 2022, 14, 2845. [Google Scholar] [CrossRef]
- Fadiji, T.; Rashvand, M.; Daramola, M.O.; Iwarere, S.A. A review on antimicrobial packaging for extending the shelf life of food. Processes 2023, 11, 590. [Google Scholar] [CrossRef]
- Ge-Zhang, S.; Song, M.; Huang, Z.; Li, M.; Mu, L. Comparison and optimization: Research on the structure of the PET bottle bottom based on the finite element method. Polymers 2022, 14, 3174. [Google Scholar] [CrossRef]
- Thuy, V.T.T.; Hao, L.T.; Jeon, H.; Koo, J.-M.; Park, J.; Lee, E.S.; Hwang, S.Y.; Choi, S.; Park, J.; Oh, D. Sustainable, self-cleaning, transparent, and moisture/oxygen-barrier coating films for food packaging. Green. Chem. 2021, 23, 2658–2667. [Google Scholar] [CrossRef]
- Realini, C.E.; Marcos, B. Active and intelligent packaging systems for a modern society. Meat Sci. 2014, 98, 404–419. [Google Scholar] [CrossRef]
- Wang, M.; Wei, Z.; Zhang, Z. Antimicrobial edible films for food preservation: Recent advances and future trends. Food Bioprocess. Technol. 2024, 17, 1391–1411. [Google Scholar] [CrossRef]
- Ge-Zhang, S.; Liu, H.; Song, M.; Wang, Y.; Yang, H.; Fan, H.; Ding, Y.; Mu, L. Advances in polyethylene terephthalate beverage bottle optimization: A mini review. Polymers 2022, 14, 3364. [Google Scholar] [CrossRef]
- Omerović, N.; Djisalov, M.; Živojević, K.; Mladenović, M.; Vunduk, J.; Milenković, I.; Knežević, N.; Gadjanski, I.; Vidić, J. Antimicrobial nanoparticles and biodegradable polymer composites for active food packaging applications. Compr. Rev. Food Sci. Food Saf. 2021, 20, 2428–2454. [Google Scholar] [CrossRef]
- Flórez, M.; Guerra-Rodríguez, E.; Cazón, P.; Vázquez, M. Chitosan for food packaging: Recent advances in active and intelligent films. Food Hydrocoll. 2022, 124, 107328. [Google Scholar] [CrossRef]
- Díaz-Montes, E.; Castro-Muñoz, R. Trends in chitosan as a primary biopolymer for functional films and coatings manufacture for food and natural products. Polymers 2021, 13, 767. [Google Scholar] [CrossRef]
- Aranaz, I.; Alcántara, A.R.; Civera, M.C.; Arias, C.; Elorza, B.; Caballero, A.H.; Acosta, N. Chitosan: An overview of its properties and applications. Polymers 2021, 13, 3256. [Google Scholar] [CrossRef]
- Oun, A.A.; Shin, G.H.; Rhim, J.-W.; Kim, J.T. Recent advances in polyvinyl alcohol-based composite films and their applications in food packaging. Food Packag. Shelf Life 2022, 34, 100991. [Google Scholar] [CrossRef]
- Cong, R.; Cai, T.; Ge-Zhang, S.; Yang, H.; Zhang, C. Fabrication of PVA–Silica Sol Wood Composites via Delignification and Freezing Pretreatment. Polymers 2024, 16, 1949. [Google Scholar] [CrossRef]
- Cazón, P.; Vázquez, M.; Velazquez, G. Cellulose-glycerol-polyvinyl alcohol composite films for food packaging: Evaluation of water adsorption, mechanical properties, light-barrier properties and transparency. Carbohydr. Polym. 2018, 195, 432–443. [Google Scholar] [CrossRef]
- Kariminejad, M.; Zibaei, R.; Kolahdouz-Nasiri, A.; Mohammadi, R.; Mortazavian, A.M.; Sohrabvandi, S.; Khanniri, E.; Khorshidian, N. Chitosan/polyvinyl alcohol/SiO2 nanocomposite films: Physicochemical and structural characterization. Biointerface Res. Appl. Chem. 2022, 12, 3725–3734. [Google Scholar]
- Bonilla, J.; Fortunati, E.; Atarés, L.; Chiralt, A. Physical, structural and antimicrobial properties of poly vinyl alcohol–chitosan biodegradable films. Food Hydrocoll. 2014, 35, 463–470. [Google Scholar] [CrossRef]
- Zheng, H.; Du, Y.; Yu, J.; Huang, R.; Zhang, L. Preparation and characterization of chitosan/poly (vinyl alcohol) blend fibers. J. Appl. Polym. Sci. 2001, 80, 2558–2565. [Google Scholar] [CrossRef]
- Liu, Y.; Wang, S.; Lan, W. Fabrication of antibacterial chitosan-PVA blended film using electrospray technique for food packaging applications. Int. J. Biol. Macromol. 2018, 107, 848–854. [Google Scholar] [CrossRef]
- Chelu, M.; Moreno, J.C.; Atkinson, I.; Cusu, J.P.; Rusu, A.; Bratan, V.; Aricov, L.; Anastasescu, M.; Seciu-Grama, A.-M.; Musuc, A.M. Green synthesis of bioinspired chitosan-ZnO-based polysaccharide gums hydrogels with propolis extract as novel functional natural biomaterials. Int. J. Biol. Macromol. 2022, 211, 410–424. [Google Scholar] [CrossRef]
- Salama, A.; Abouzeid, R.E.; Owda, M.E.; Cruz-Maya, I.; Guarino, V. Cellulose–silver composites materials: Preparation and applications. Biomolecules 2021, 11, 1684. [Google Scholar] [CrossRef]
- Huang, Y.; Mei, L.; Chen, X.; Wang, Q. Recent developments in food packaging based on nanomaterials. Nanomaterials 2018, 8, 830. [Google Scholar] [CrossRef] [PubMed]
- Muhammud, A.M.; Gupta, N.K. Nanostructured SiO2 material: Synthesis advances and applications in rubber reinforcement. RSC Adv. 2022, 12, 18524–18546. [Google Scholar] [CrossRef] [PubMed]
- Alimunnisa, J.; Ravichandran, K.; Meena, K.S. Synthesis and characterization of Ag@ SiO2 core-shell nanoparticles for antibacterial and environmental applications. J. Mol. Liq. 2017, 231, 281–287. [Google Scholar] [CrossRef]
- Al-Tayyar, N.A.; Youssef, A.M.; Al-Hindi, R.R. Antimicrobial packaging efficiency of ZnO-SiO2 nanocomposites infused into PVA/CS film for enhancing the shelf life of food products. Food Packag. Shelf Life 2020, 25, 100523. [Google Scholar] [CrossRef]
- Siddiqui, J.; Taheri, M.; Alam, A.U.; Deen, M.J. Nanomaterials in smart packaging applications: A review. Small 2022, 18, 2101171. [Google Scholar] [CrossRef]
- Cheng, P.; Ziegler, M.; Ripka, V.; Wang, D. Bio-inspired self-assembly of large area 3D Ag@ SiO2 plasmonic nanostructures with tunable broadband light harvesting. Appl. Mater. Today 2021, 25, 101238. [Google Scholar] [CrossRef]
- Ge-Zhang, S.; Yang, H.; Mu, H. Interfacial solar steam generator by MWCNTs/carbon black nanoparticles coated wood. Alex. Eng. J. 2023, 63, 109176. [Google Scholar] [CrossRef]
- van Esch, J.A.; Koldenhof, E.E.; van Doorn, A.J.; Koenderink, J.J. Spectral sensitivity and wavelength discrimination of the human peripheral visual field. JOSA A 1984, 1, 443–450. [Google Scholar] [CrossRef]
- Kanatt, S.R.; Rao, M.S.; Chawla, S.P.; Sharma, A. Active chitosan–polyvinyl alcohol films with natural extracts. Food Hydrocoll. 2012, 29, 290–297. [Google Scholar] [CrossRef]
- Chen, C.; Ding, R.; Yang, S.; Wang, J.; Chen, W.; Zong, L.; Xie, J. Development of thermal insulation packaging film based on poly (vinyl alcohol) incorporated with silica aerogel for food packaging application. LWT 2020, 129, 109568. [Google Scholar] [CrossRef]
- Hao, H.; Sheng, Q.; Zheng, J. One-step synthesis of Ag@ SiO2@ Ag nanomaterial and its application as hydrogen peroxide sensor. Colloids Surf. A Physicochem. Eng. Asp. 2017, 518, 124–129. [Google Scholar] [CrossRef]
- Wang, J.; Liang, J.; Sun, L.; Gao, S. PVA/CS and PVA/CS/Fe gel beads’ synthesis mechanism and their performance in cultivating anaerobic granular sludge. Chemosphere 2019, 219, 130–139. [Google Scholar] [CrossRef] [PubMed]
- Kumar, H.N.; Prabhakar, M.; Prasad, C.V.; Rao, K.M.; Reddy, T.A.K.; Rao, K.C.; Subha, M. Compatibility studies of chitosan/PVA blend in 2% aqueous acetic acid solution at 30 °C. Carbohydr. Polym. 2010, 82, 251–255. [Google Scholar] [CrossRef]
- Choo, K.; Ching, Y.C.; Chuah, C.H.; Julai, S.; Liou, N.-S. Preparation and characterization of polyvinyl alcohol-chitosan composite films reinforced with cellulose nanofiber. Materials 2016, 9, 644. [Google Scholar] [CrossRef] [PubMed]
- Zhang, K.; Liu, Y.; Shi, X.; Zhang, R.; He, Y.; Zhang, H.; Wang, W. Application of polyvinyl alcohol/chitosan copolymer hydrogels in biomedicine: A review. Int. J. Biol. Macromol. 2023, 242, 125192. [Google Scholar] [CrossRef] [PubMed]
- Zhao, J.; Qian, J.; Luo, J.; Huang, M.; Yan, W.; Zhang, J. Application of Ag@ SiO2 nanoparticles within PVA to reduce growth of E. coli and S. aureus in beef patties. J. Food Sci. 2022, 87, 4569–4579. [Google Scholar] [CrossRef]
- Tang, S.; Zheng, J. Antibacterial activity of silver nanoparticles: Structural effects. Adv. Healthc. Mater. 2018, 7, 1701503. [Google Scholar] [CrossRef] [PubMed]
- Li, W.-R.; Xie, X.-B.; Shi, Q.-S.; Duan, S.-S.; Ouyang, Y.-S.; Chen, Y.-B. Antibacterial effect of silver nanoparticles on Staphylococcus aureus. Biometals 2011, 24, 135–141. [Google Scholar] [CrossRef]
- Liu, F.; Zhang, X.; Xiao, X.; Duan, Q.; Bai, H.; Cao, Y.; Zhang, Y.; Alee, M.; Yu, L. Improved hydrophobicity, antibacterial and mechanical properties of polyvinyl alcohol/quaternary chitosan composite films for antibacterial packaging. Carbohydr. Polym. 2023, 312, 120755. [Google Scholar] [CrossRef]
- Bana, R.; Banthia, A.K. Mechanical and thermal analysis of poly (Vinyl-Alcohol) and modified wood dust composites. J. Wood Chem. Technol. 2011, 31, 218–232. [Google Scholar] [CrossRef]
- Ge-Zhang, S.; Cai, T.; Yang, H.; Ding, Y.; Song, M. Biology and nature: Bionic superhydrophobic surface and principle. Front. Bioeng. Biotechnol. 2022, 10, 1033514. [Google Scholar] [CrossRef] [PubMed]
- Ge-Zhang, S.; Yang, H.; Ni, H.; Mu, H.; Zhang, M. Biomimetic superhydrophobic metal/nonmetal surface manufactured by etching methods: A mini review. Front. Bioeng. Biotechnol. 2022, 10, 958095. [Google Scholar] [CrossRef]
- Chi, C.; Qu, P.; Xu, X.; Xian, J.; Zhang, D.; Li, J.; Ren, J.; Xu, X.; Chen, H. Synthesis of SiO2@Ag for light absorption and the fabrication of highly color-saturated amorphous photonic crystals. J. Mater. Chem. C 2023, 11, 13343–13349. [Google Scholar] [CrossRef]

| Sample | Tensile Strength (MPa) | Elongation at Break (%) |
|---|---|---|
| Pure PVA | 14.6 | 217.5 |
| CS:PVA = 10:90 | 16.3 | 173.4 |
| CS:PVA = 20:80 | 18.8 | 128.3 |
| CS:PVA = 30:70 | 20.9 | 112.6 |
| CS:PVA = 40:60 | 22.1 | 88.7 |
| Pure CS | 28.4 | 28.2 |
| Ag/SiO2-CS/PVA | 25.5 | 76.7 |
Disclaimer/Publisher’s Note: The statements, opinions and data contained in all publications are solely those of the individual author(s) and contributor(s) and not of MDPI and/or the editor(s). MDPI and/or the editor(s) disclaim responsibility for any injury to people or property resulting from any ideas, methods, instructions or products referred to in the content. |
© 2024 by the authors. Licensee MDPI, Basel, Switzerland. This article is an open access article distributed under the terms and conditions of the Creative Commons Attribution (CC BY) license (https://creativecommons.org/licenses/by/4.0/).
Share and Cite
Cai, T.; Ge-Zhang, S.; Zhang, C.; Mu, P.; Cui, J. Excellent Antibacterial Properties of Silver/Silica–Chitosan/Polyvinyl Alcohol Transparent Film. Int. J. Mol. Sci. 2024, 25, 8125. https://doi.org/10.3390/ijms25158125
Cai T, Ge-Zhang S, Zhang C, Mu P, Cui J. Excellent Antibacterial Properties of Silver/Silica–Chitosan/Polyvinyl Alcohol Transparent Film. International Journal of Molecular Sciences. 2024; 25(15):8125. https://doi.org/10.3390/ijms25158125
Chicago/Turabian StyleCai, Taoyang, Shangjie Ge-Zhang, Chang Zhang, Pingxuan Mu, and Jingang Cui. 2024. "Excellent Antibacterial Properties of Silver/Silica–Chitosan/Polyvinyl Alcohol Transparent Film" International Journal of Molecular Sciences 25, no. 15: 8125. https://doi.org/10.3390/ijms25158125
APA StyleCai, T., Ge-Zhang, S., Zhang, C., Mu, P., & Cui, J. (2024). Excellent Antibacterial Properties of Silver/Silica–Chitosan/Polyvinyl Alcohol Transparent Film. International Journal of Molecular Sciences, 25(15), 8125. https://doi.org/10.3390/ijms25158125

